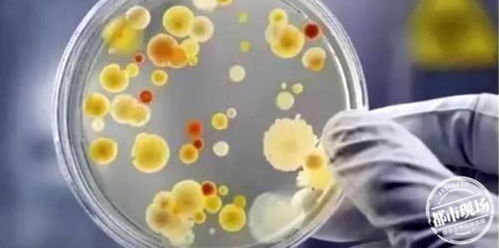
深圳人工流产，了解、关怀与支持

亲爱的读者,今天我们要探讨一个既敏感又重要的话题——深圳人工流产,这是一个涉及个人健康、情感和道德选择的复杂问题,我们将以友好、清晰和富有同情心的语气,帮助您深入理解这一话题,并提供实用的见解和建议。
让我们从基础开始,人工流产,也称为堕胎,是指在怀孕早期通过医疗手段终止妊娠的过程,这是一个在全球范围内广泛讨论的话题,涉及到法律、伦理和个人选择等多个层面,在深圳,这一话题同样备受关注,因为它关系到无数女性的健康和未来。
人工流产的医学解释
为了更好地理解这一过程,我们可以将其比作一个“生命的暂停键”,怀孕是一个自然的生理过程,但在某些情况下,女性可能因为健康、经济或个人原因选择终止妊娠,人工流产手术通常在怀孕的前12周内进行,此时胚胎尚未发育成熟,手术相对简单且安全。
深圳的法律与政策
在深圳,人工流产是合法的,但必须在符合法律规定和医疗标准的情况下进行,这意味着女性需要在专业医疗机构接受手术,并且必须遵循一定的程序和规定,这些法律和政策旨在保护女性的身体健康和权益,同时也确保手术的安全性。
情感与道德考量
人工流产是一个涉及情感和道德选择的问题,每个女性在面对这一决定时,都可能经历复杂的情感波动,她们可能会感到害怕、内疚或不确定,在这种情况下,理解和支持变得尤为重要,我们应该提供一个安全、无偏见的环境,让她们能够自由地表达自己的感受,并做出最适合自己的决定。
社会支持与资源
在深圳,有许多组织和资源可以为需要人工流产的女性提供帮助,这些包括专业的医疗机构、心理咨询服务和法律援助,了解这些资源的存在和如何获取它们,对于需要帮助的女性来说至关重要。
预防意外怀孕
预防意外怀孕是减少人工流产需求的关键,在深圳,性教育和避孕知识的普及是预防意外怀孕的重要手段,通过教育,我们可以提高人们对性健康的认识,减少意外怀孕的风险。
面对人工流产的建议
如果您或您认识的人正面临这一决定,以下是一些建议:
1、寻求专业意见:咨询医生或专业人士,了解手术的风险和后果。
2、情感支持:与信任的朋友或家人分享您的感受,寻求情感支持。
3、了解法律:确保您了解深圳的法律和政策,以保护自己的权益。
4、利用资源:利用深圳提供的资源,如心理咨询和法律援助。
5、做出决定:在充分了解所有信息后,做出最适合自己的决定。
深圳人工流产是一个复杂而敏感的话题,它涉及到个人选择、健康和法律等多个方面,通过这篇文章,我们希望为您提供一个全面而深入的视角,帮助您更好地理解和应对这一问题,无论您的立场如何,理解和支持都是我们共同的责任,让我们共同努力,为所有女性创造一个更加健康、安全和支持的环境。
希望这篇文章能够为您提供切实的帮助和启发,如果您有任何问题或需要进一步的信息,请随时联系我们,我们在这里,为您提供支持和帮助。








